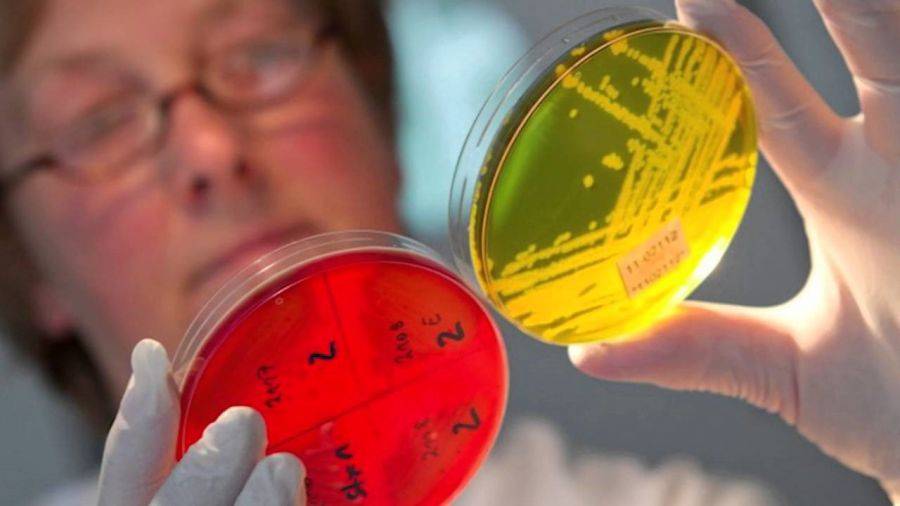

Питание во время лечения
Питание подбирается с учетом возраста ребенка и его состояния. Но вся пища должна легко усваиваться и быстро перевариваться. Для детей старшего возраста из меню исключают:
- молоко;
- жирную, острую, соленую пищу;
- жареные продукты;
- сырые овощи или фрукты;
- копчености.
Это связано со сниженной ферментативной функцией организма. ЖКТ просто не сможет переварить и усвоить такую пищу, а это ухудшит состояние ребенка. Но перевести ребенка на голодание, как это рекомендуют взрослым, невозможно. Во-первых, малыш просто не выдержит двух дней голодовки. Во-вторых, это опасно для детей с низкой массой тела. Поэтому следует тщательно подбирать рацион. Лучше, если он будет вегетарианским, на основе круп и с добавлением овощей. Их можно отваривать или готовить на пару, запекать в духовке без масла и острых специй.
Грудничкам рекомендуют употребление кисломолочных смесей. При вирусной инфекции им нужно заменить обычную молочную смесь на низколактозную. В идеале вообще заменить ее на безлактозную. После лечения обязательно добавить в рацион смеси с бифидо- и лактобактериями.
Симптомы острой кишечной инфекции
У детей инкубационный период заболевания короткий, от 30 минут до нескольких часов. В подростковом возрасте первые проявления инфекции могут возникнуть через сутки после заражения (зависит от возбудителя, степени поражения, иммунитета организма).
Признаки острой кишечной инфекции у детей однотипны, независимо от вида патогенной микрофлоры. Болезнь начинается остро. Первые симптомы со стороны пищеварительной системы, затем у детей нарастает обезвоживание всего организма. Клиника развивается на фоне тяжелой интоксикации.
Поражение ЖКТ
Патологический процесс развивается в слизистой кишечника и приводит к функциональным нарушениям и морфологическим изменениям.
- сбои в выработке ферментов влечет недостаточное расщепление пищи;
- из-за воспаленной слизистой оболочки нарушается процесс всасывания питательных веществ, воды, электролитов;
- нарушение моторики и перистальтики всех отделов кишечника.
Морфологические или структурные изменения – гиперемия слизистой, истончение эпителия, образование язв на стенках, отмирание (некроз) небольших участков внутренней оболочки.
Кишечный синдром у детей проявляется реакцией органов пищеварения на инфекционный агент:
- со стороны желудка (гастрит) – тошнота, однократная или многократная рвота, не приносящая облегчения, тяжесть в эпигастральной области, появление рвотного рефлекса на попытки приема воды или пищи, у младенцев моментальное срыгивание после приема грудного молока или детской смеси;
- со стороны тонкого кишечника (энтерит) – вздутие живота, боль разной интенсивности в области пупка при надавливании на брюшную стенку, урчание в кишечнике;
- со стороны толстого кишечника – профузный понос, стул жидкий, содержит примеси, болезненность при испражнении, боли по периметру живота, отдают в прямую кишку, спазмы, ложные позывы акта дефекации.
Обезвоживание
Стремительное обезвоживание – опасный симптом для детского организма. Недостаток воды ведет к угнетению работы почек, печени, головного мозга. Быстро изменяется количественный и качественный состав крови, что приводит к нарушению внутриклеточного обмена. Нехватка жидкости способствует росту концентрации токсических веществ в организме, а интоксикационное отравление может стать причиной летального исхода болезни.
Как распознать признаки обезвоживания у маленьких детей:
- сухая слизистая оболочка рта и носа, пересохшие губы, из-за недостаточной выработки слюны выражены глотательные движения, язык выступает наружу;
- вязкая слюна;
- отсутствие слезной жидкости – ребенок плачет без слез;
- из-за нарушения работы почек мочеиспускание реже 1 раза в 2 часа;
- рвота, понос, потоотделение – признаки обезвоживания;
- сухая кожа, самостоятельно собирается в складки.
Интоксикация
Токсины, вырабатываемые бактериями, быстро попадают в кровеносное русло и разносятся по всему организму ребенка. Наличие в крови токсических веществ приводит к повышению температуры тела, вызывает боль и ломоту в мышцах, костях. У малышей могут проявляться судорожные сокращения в конечностях. Из-за повышенного мышечного тонуса голова запрокинута назад, веки плохо смыкаются. Важным симптомом интоксикации является изменение цвета кожи. Покровы становятся бледными, с синим оттенком, холодными на ощупь. На коже могут появляться пятна.
Сбой работы почек провоцирует повышение ацетона в крови. Это влияет на рвотный центр в головном мозге и вызывает рвоту, не связанную с поражением ЖКТ. В тяжелых случаях поражаются крупные нервы и стволы – нейротоксикоз. Для такого состояние характерно нарушение сознания, вплоть до его потери, сильные головные боли, нарушение двигательной активности, острая чувствительность к звукам и свету.
Сыпь
- пустулезная – гнойничковые образования округлой формы, на поверхности располагается белое или желтоватое образование (гной), локализуется преимущественно на лице, шее, спине, проявляется при стафилококковой инфекции;
- пятнисто-папулезная – сыпь , которая немного приподнимается над кожей, красного, розового цвета, иногда с коричневым оттенком, элементы могут сливаться и образовывать большие пятна, локализуется не только на коже, но и на слизистых оболочках, проявляется при ротавирусной инфекции;
- скарлатиноподобная – мелкая, точечная сыпь по всему телу, ярко-красного цвета, наибольшая сосредоточенность на лице и шее, проявляется при инфекции, вызванными грамотрицательными бактериями (шигелла).
Лечение ротавирусной инфекции
В большинстве случаев организм как взрослых, так и детей самостоятельно справляется с ротавирусом, и в течение недели происходит выздоровление.
Однако повышение температуры, появление повторной рвоты, поноса и боли в животе всегда является уважительным поводом для вызова врача на дом, особенно если речь идет о заболевании ребенка. Это связано с тем, что похожие симптомы характерны не только для ротавирусного гастроэнтерита, но и для более серьезных кишечных инфекций, а также хирургических заболеваний, например, аппендицита
Поэтому важно, чтобы врач осмотрел больного и исключил опасные для жизни и здоровья состояния
Легкие формы ротавирусной инфекции лечатся дома. Врач может назначить ряд лекарственных средств, которые помогут быстрее справиться с симптомами кишечного гриппа, облегчить состояние и, главное, избежать осложнений и перехода болезни в тяжелую форму. В тяжелых случаях рекомендуется госпитализация в инфекционную больницу.
Диета при ротавирусной инфекции
В первый день болезни, при частой рвоте и отсутствии аппетита от еды можно воздержаться. Однако, как только самочувствие начинает улучшаться, нужно постепенно вернуться к полноценному питанию, чтобы ускорить выздоровление
На протяжении всей болезни важно пить как можно больше жидкости
При развитии инфекции у детей грудного возраста их продолжают кормить, как и прежде: грудным молоком или специальными смесями. Рекомендуется лишь увеличить частоту кормления. В некоторых случаях врач может посоветовать использование пищевых добавок или лекарств, содержащих лактазу. Это фермент, расщепляющий молоко и помогающий его усвоению, что особенно актуально для грудничков. Известно, что при ротавирусной инфекции активность собственной лактазы в организме снижается, что приводит к плохому усвоению молочных продуктов, усилению поноса и вздутию живота.
Старшим детям и взрослым желательно увеличить кратность приема пищи, сократив размер порции. Из диеты исключают молочные продукты, снеки, полуфабрикаты, ограничивают употребление соков, сырых фруктов и овощей, бобовых и другой пищи, богатой углеводами.
Наиболее предпочтительными являются каши, жидкие супы, отварные суфле, паровые котлеты, вчерашний хлеб. Нельзя употреблять жареные, острые, маринованные и копченые продукты. Такую диету нужно соблюдать до полного выздоровления и в течение 2-3 дней после.
Лекарственное лечение ротавирусной инфекции
Чтобы помочь организму быстрее справиться с вирусом можно использовать противовирусные препараты, например: Арбидол, Виферон и другие. Особенность такого лечения заключается в необходимости начать прием лекарства с первыми симптомами кишечного гриппа. Иначе эффективность противовирусных средств снижается. Также противовирусную защиту усиливают средства, стимулирующие иммунитет: Циклоферон, Антиротавирусный иммуноглобулин, Комплексный иммуноглобулиновый препарат (КИП) и другие. Перед применением желательно проконсультироваться с врачом.
Антибиотики при ротавирусной инфекции не показаны. В редких случаях их может назначить врач при высоком риске бактериальных осложнений или смешанных инфекциях (когда помимо ротавируса обнаруживается заражение бактериями).
Для борьбы с интоксикацией и поносом назначаются сорбенты. Это лекарственные средства, которые способны всасывать своей поверхностью токсины и газы из желудочно-кишечного тракта. Многие из них обладают закрепляющим действием, то есть нормализуют стул. В аптеке без рецепта можно купить такие сорбенты, как: Смекта, Полисорб, уголь активированный, Фильтрум-СТИ и др. Сорбенты нужно принимать отдельно от других лекарств, с интервалом не менее 30 минут.
Чтобы разгрузить желудочно-кишечный тракт и ускорить восстановление его полноценной работы назначаются ферментные препараты, которые принимают во время еды. Это Креон, Панкреатин, Мезим, Лактаза и др. Кроме того, в лечении ротавирусного гастроэнтерита широко используются препараты про- и пребиотиков: Энтерол, Бактисуптил, Бифиформ, Линекс, Ацилакт и др.
Образ жизни и профилактика питания во время кишечного инфицирования
Режим во время острой фазы заболевания должен быть обязательно постельный, с максимально возможной изоляцией больного от окружающих. Если врач направляет вашего ребёнка в стационар, лучше так и сделать. Так вы предотвратите заражение всех членов вашей семьи и избежите осложнений, которые просто по незнанию можете не заметить. Особенно это касается детей возрастом до 2 лет.
В инфекционном отделении медицинского учреждения вас направят в специальный изолированный бокс, чтобы избежать суперинфицирования, где проведут все необходимые исследования, назначат лечение и соответствующее питание.
В случае когда течение болезни происходит в средней или лёгкой форме, ребёнку больше 7 лет, врач соглашается оставить его на амбулаторное лечение, в качестве профилактики несварения пищи необходимо организовать соответствующее питание.

В острую фазу болезни показаны слизистые супы, лёгкие мясные бульоны, отварная нежирная рыба, каши, белый чёрствый хлеб, сухари, сухое несдобное печенье, печеные яблоки без кожуры, кисель, обезжиренный кефир. Через 4–5 дней можно вводить протёртое нежирное мясо, омлет, протёртые варёные яйца.
Нужно исключить: молоко, пряности, приправы, консервы, копчёности, чеснок, зелёный лук
На общий стол переводят осторожно и постепенно в течение 3–4 недель
Грудничков кормят кисломолочными смесями. В случае с вирусным инфицированием или повышенным газообразование переводят на безлактозное питание. После выздоровления полезно некоторое время «посидеть» на смесях с добавлением бифидо и лактобактерий.
Осложнения острой кишечной инфекции
Многих инфекций можно избежать, если соблюдать правила.
- Укрепление иммунной защиты – первое требование. Поэтому педиатры настоятельно не рекомендуют прекращать грудное вскармливание до года. Это защитит малыша от инфекций и будущих болезней.
- Гигиена. Касается не только самого ребенка, но и других членов семьи. Посуда, одежда, детские пеленки – все должно быть чистым. Даже упавшую соску следует сначала промыть кипятком и продезинфицировать, а только потом давать младенцу.
- Если у грудничка появились первые симптомы заболевания, следует тут же обратиться к врачу. Заниматься самолечением не рекомендуется.
- Придерживаться диеты следует и самой маме. Употреблять в пищу нужно только полезные продукты, побольше круп, фруктов, овощей, хлеба из муки грубого помола. А вот сладкое, сдобу следует ограничить. Мыть овощи и фрукты надо тщательно и кипятком. Особенно это касается летнего периода, когда риск подцепить инфекцию возникает.
При неправильном/несвоевременном осуществлении терапии может возникнуть обезвоживание организма, нарушение нормальной деятельности внутренних органов, дисбактериоз кишечника, а также снижение защиты иммунной системы. Тяжелое течение патологии приводит к появлению следующих осложнений:
- нейротоксикоз – у пациента наблюдается расстройство сознание, нарушение сна, возможны галлюцинации и судороги;
- расстройство кровообращения – понижается артериальное давление, кожные покровы становятся бледными, формируются проблемы сердечно-сосудистой системы;
- почечная недостаточность – скудное выделение мочи, тупые боли в пояснице;
- гиповолемический шок – развивается вследствие дегидратации, западание глаз, уменьшение веса.
Если халатно отнестись к лечению кишечной инфекции, она может спровоцировать развитие серьезных осложнений
Чтобы предупредить инфицирование ОКИ, ребенку с ранних лет нужно прививать чистоплотность. В качестве профилактики достаточно соблюдать элементарные правила личной гигиены:
- мытье рук перед едой, а также после посещения туалета, общественных мест, уличных прогулок;
- гигиеническая обработка фруктов/овощей.
После каждого посещения туалета, унитаз/детский горшок обрабатывают дезинфицирующим средством. Контакт со здоровыми членами семьи следует свести к минимуму.
Чтобы предупредить появление симптомов кишечной инфекции у грудничка, нужно соблюдать следующие правила:
Все предметы, окружающие ребенка, и руки родителей всегда должны быть чистыми. Не нужно лениться каждый раз мыть руки после прогулки или сна и ополаскивать упавшую на пол пустышку. Грудь перед каждым кормлением малыша следует обрабатывать слабым содовым раствором, при этом молодая мама должна не забывать ежедневно принимать душ и менять нательное белье
Если в семье кто-то страдает кишечным расстройством, важно свести к минимуму контакт с этим членом семьи до полного выздоровления. Влажная уборка и проветривание в помещении должны проводиться как можно чаще. Искусственное питание для грудничка нужно готовить на основе бутилированной детской воды
Искусственное питание для грудничка нужно готовить на основе бутилированной детской воды.
Кишечная инфекция в раннем возрасте встречается достаточно часто. Болезнетворная микрофлора попадает в организм ребенка при контакте с больным человеком, при употреблении некачественной пищи или из-за несоблюдения элементарных правил гигиены. У грудничков болезнь протекает тяжело. При первых симптомах кишечной инфекции у грудничка — высокой температуре, многократной рвоте и диарее — рекомендуется срочно обратиться за медицинской помощью и начать лечение.
Диагностика кишечной инфекции у детей
Изначально диагностирование проблемы происходит в несколько этапов. Необходимо поинтересоваться у мамы общей клинической картины протекания болезни. Мама должна наблюдать как можно тщательнее за своим ребенком, чтобы с высокой долью точности сообщить о том, что болит у малыша.
После осмотра специалиста и маминых исследований, врач ставит первичный диагноз. Он может быть не столь точным, поскольку не опирается на подтвержденные лабораторные анализы.
Тут же специалист выписывает направления на проведение:
- бактериологические посевы – их берут из дефекаций или рвотных масс, воды, с помощью которой промывали желудок;
- серологические методы – с помощью которых происходит обнаружение в крови микроорганизм или специфических тел;
- полимеразная цепная реакция – скорый анализ, результат на наличие грибков и бактерий которых получают сразу же на месте.
Это самые популярные методы диагностирования, которые являются эффективными, подтверждают или опровергают изначально поставленный диагноз.
Обзор лекарств для лечения кишечных инфекций
Нифуроксазид (энтерофурил)
Безрецептурное противомикробное средство широкого спектра действия, производное 5‑нитрофурана. Антимикробная активность нифуроксазида вызвана наличием в его составе NO2‑группы, которая угнетает активность дегидрогеназы и нарушает синтез белков в патогенных бактериях.
Нифуроксазид не оказывает действия на сапрофитную флору, не нарушает равновесия нормальной кишечной флоры. При острой бактериальной диарее восстанавливает эубиоз кишечника. При инфицировании энтеротропными вирусами препятствует развитию бактериальной суперинфекции. Этот препарат для лечения кишечной инфекции можно назначать беременным и кормящим женщинам, детям начиная с одного месяца. Терапия нифуроксазидом не должна превышать 7 дней, при этом запрещено употреблять алкоголь.
Безрецептурный препарат в форме вагинальных и ректальных суппозиториев. Обладает иммуномодулирующим, противовирусным, антихламидийным действием. Кипферон — комплексная лекарственная форма, содержащая человеческий рекомбинантный интерферон-α2 и комплексный иммуноглобулиновый препарат (КИП). Разрешен к применению у детей на первом году жизни.
Ко-тримоксазол (сульфаметоксазол + триметоприм)
Механизм действия ко-тримоксазола обусловлен двойным блокированием метаболизма микроорганизмов. Триметоприм обратимо ингибирует дигидрофолатредуктазу микроорганизмов, нарушает образование из дигидрофолиевой кислоты тетрагидрофолиевой, продукцию нуклеиновых кислот, пиримидиновых и пуриновых оснований; подавляет размножение и рост бактерий. Сульфаметоксазол, который по строению схож с парааминобензойной кислотой, захватывается бактерией и препятствует включению парааминобензойной кислоты в дигидрофолиевую кислоту. В связи с тем что ко-тримоксазол угнетает жизнедеятельность кишечной палочки, снижается образование в кишечнике никотиновой кислоты, рибофлавина, тиамина и прочих витаминов B-комплекса. Это лекарство, помогающее от кишечной инфекции, отпускается по рецепту, применяется с 2‑месячного возраста.
Бактисубтил — споры бактерий Bacillus cereus IP. Рецептурный препарат от кишечной инфекции бактисубтил сохраняет и корригирует физиологическое равновесие кишечной флоры. Споры бактерий, содержащиеся в препарате, устойчивы к действию желудочного сока. Прорастание бактерий в вегетативные формы происходит в кишечнике, затем они высвобождают энзимы, которые расщепляют углеводы, жиры, белки. В результате образуется кислая среда, предотвращающая процессы гниения. Препарат препятствует нарушению синтеза витаминов группы В и Р в кишечнике, его нельзя запивать горячим, а также сочетать с алкоголем. Детям его назначают с семилетнего возраста. Бактисубтил резистентен к действию различных антибиотиков и сульфаниламидных препаратов, поэтому может быть назначен одновременно с ними.
Декстроза + калия хлорид + натрия хлорид + натрия цитрат (регидрон)
Регидратирующее средство для перорального приема восстанавливает водно-электролитное равновесие, нарушенное при обезвоживании организма; корректирует ацидоз. Содержимое одного пакетика растворяют в литре свежепрокипяченной охлажденной питьевой воды. Приготовленный раствор нужно хранить в холодильнике и использовать в течение 24 часов. В раствор нельзя добавлять никакие другие компоненты, чтобы не нарушить действие препарата. Отпускается без рецепта.
Безрецептурное лекарственное средство природного происхождения, обладающее протективным действием в отношении слизистой оболочки кишечника и выраженными адсорбирующими свойствами. Являясь стабилизатором слизистого барьера, образует поливалентные связи с гликопротеинами слизи и увеличивает продолжительность ее жизни, образуя физический барьер, который защищает слизистую оболочку пищеварительного тракта от отрицательного действия ионов Н+, соляной кислоты, желчных солей, микроорганизмов, их токсинов и других раздражителей. Обладает селективными сорбционными свойствами, защищает слизистую оболочку пищеварительного тракта от отрицательного воздействия. В терапевтических дозах не влияет на моторику кишечника.
Профилактика
Защитить
ребенка от
заражения бактериальным или вирусным возбудителем полностью невозможно. Но
можно уменьшить такую вероятность.
Правила
для предотвращения кишечной
инфекции у детей:
- Соблюдение личной гигиены. Руки следует
мыть с мылом после любого контакта с потенциально загрязненными поверхностями
(посещение общественных мест, туалета, контакт с животными или грязной почвой). - Пейте только чистую воду. Лучший вариант
— бутилированная. Если приобретать такой продукт нет возможности, лучше
кипятить имеющуюся воду. Грудничкам, которым не исполнился 1 год, пить сырую воду не
рекомендуют. Осторожными нужно быть с выбором питьевой воды в периоды посещения
экзотических стран. - Нежелательно готовить консервацию из
мяса, рыбы или грибов дома. При неправильной обработке продуктов или нарушении
техники изготовления консервов происходит быстрое размножение патогенных
бактерий. Домашние консервы со вздутыми крышками подлежат утилизации. По этой
же причине следует избегать употребления вяленой рыбы в теплые периоды года. - Правильно обрабатывайте продукты
питания. Сырые овощи тщательно вымывать, а все, что подлежит термическому
воздействию, хорошо проваривать (жарить, печь). Высокие температуры губительны
для возбудителей инфекции. - Не употребляйте продукты с истекшим сроком
годности, нарушением правил хранения, нарушенной целостностью упаковки.
Особенно тщательно нужно проверять молочные и яичные продукты. Они часто
становятся причиной острого отравления. - Храните готовую еду в холодильнике при
температуре не более +2+4 градусов. При отметке +10 происходит размножение
бактерий. - Храните продукты в защищенном от
грызунов и насекомых месте. Мухи и мыши являются переносчиками бактерий. - Готовая еда не должна находиться в
холодильнике более 3 дней. Для молочных, яичных, мясных и рыбных блюд — срок
максимального хранения 2 суток. - Соблюдайте пищевое
«соседство». Приготовленные продукты следует держать подальше от
сырых. - Не допускайте контакта с потенциальными
носителями инфекции.
Чем младше заболевший, тем сложнее течение болезни, больше риск развития
осложнений.
Защититься
от ротавируса можно с помощью вакцинации. Вакцина вводится перорально. Иммунная
защита сохраняется 3-4 года.
Кишечные
инфекции
— болезни, которые опасны для маленьких детей. Недопустимо проводить самостоятельное лечение. При серьезной
патологии органов пищеварения промедление с правильным лечением приводит к опасным последствиям.
Медикаментозное лечение
Лекарственные средства, предназначенные для лечения кишечной инфекции, назначаются врачом на основании лабораторных исследований, посредством которых выявляется тип возбудителя заболевания. Так, если инфекция носит вирусный характер, то назначаются противовирусные препараты. Если же источником заболевания явились бактерии, больному прописываются антибактериальные таблетки.
Поскольку при кишечных отравлениях наиболее выраженными оказываются симптомы интоксикации и нарушения стула, прежде всего, нужно устранить их. Это достигается путем ликвидации из организма больного патогенного агента, который стал причиной заболевания. Также необходимо нормализовать водно-электролитный баланс в кишечнике и вывести токсические вещества из организма. Для достижения последнего требуется лечить больного с помощью сорбентов.
Лечение кишечной инфекции включает прием следующих групп препаратов:
- антибиотики;
- противовирусные средства;
- сорбенты;
- лекарства от диареи;
- ферменты;
- обезболивающие.
При кишечных инфекциях, имеющих бактериальное происхождение, назначаются противомикробные средства из группы фторхинолонов, тетрациклинов, амфениколонов или метронидазолов. Это могут быть Офлоксацин, Норфлоксацин, Ципрофлоксацин, Левометицин, Доксициклин. Все виды кишечной инфекции сопровождаются образованием токсических веществ в результате деятельности патогенных микроорганизмов.
Поэтому необходимо принимать лекарственные средства для выведения их из органов ЖКТ. Для этого назначают сорбенты, они впитывают в себя вредные вещества и выводят их из кишечника в неизменном виде. Наиболее популярным препаратом этой группы является активированный уголь. Рекомендованная доза лекарства – 1 таблетка на 10 кг массы тела. Также при выраженной интоксикации назначаются Полисорб, Смекта или Энтеросгель.
Для нормализации стула и устранения диареи назначают специальные лекарства. Наименования их следующие: Тримебутин, Лоперамид, Стопдиар, Фталазол, Нифуроксазид. Прием этих препаратов будет оказывать положительное влияние на функционирование желудочно-кишечного тракта. Они способствуют снижению тонуса и перистальтики кишечника.
Если наряду с другими симптомами, кишечная инфекция сопровождается выраженным болевым синдромом, можно принять обезболивающие таблетки. Но делать это следует только после одобрения врачом, поскольку самостоятельный их прием до осмотра врача может изменить клиническую картину, что значительно затруднит диагностику. Обычно для облегчения состояния назначается Спазматон, Но-шпа или Бенальгин.
После устранения острых симптомов кишечной инфекции рекомендуется принимать ферментативные препараты для нормализации и ускорения пищеварительных процессов. В качестве таковых чаще всего назначают Мезим форте, Панкреатин или Микразим. Также необходимо восстановить микрофлору кишечника, для этого предусмотрен прием пробиотиков. Они включены в комплексное лечение кишечной инфекции как у взрослых, так и у детей.
В некоторых случаях кишечной инфекции может потребоваться применение средств экстренной помощи. Необходимость в этом возникает, когда у больного наблюдается неукротимый понос более 8 раз в день. Значение имеет и характер испражнений, настораживает водянистый и напоминающий рисовый отвар. При таких симптомах рекомендуется:
- поставить капельницу с глюкозой и изотоническим раствором хлорида натрия;
- внутримышечно ввести литическую смесь;
- принять меры для регидратации;
- обеспечить прием адсорбентов.
При пищевом отравлении также проводится промывание желудка и очистительная клизма. Эти процедуры должен назначить лечащий врач.
Кишечная инфекция требует комплексного лечения
Кишечная инфекция требует комплексного лечения
Online-консультации врачей
| Консультация радиолога (диагностика МРТ, КТ) |
| Консультация дерматолога |
| Консультация анестезиолога |
| Консультация нарколога |
| Консультация сексолога |
| Консультация андролога-уролога |
| Консультация офтальмолога (окулиста) |
| Консультация инфекциониста |
| Консультация специалиста по лечению за рубежом |
| Консультация психиатра |
| Консультация онколога-маммолога |
| Консультация гинеколога |
| Консультация невролога |
| Консультация неонатолога |
| Консультация нейрохирурга |
Новости медицины
Футбольные фанаты находятся в смертельной опасности, 31.01.2020
“Умная перчатка” возвращает силу хвата жертвам травм и инсультов, 28.01.2020
Назван легкий способ укрепить здоровье, 20.01.2020
Топ-5 салонов массажа в Киеве по версии Покупон, 15.01.2020
Новости здравоохранения
Глава ВОЗ объявил пандемию COVID-19, 12.03.2020
Коронавирус атаковал уже более 100 стран, заразились почти 120 000 человек, 11.03.2020
Коронавирус атаковал 79 стран, число жертв приближается к 3200 человек, 04.03.2020
Новый коронавирус атаковал 48 стран мира, число жертв растет, 27.02.2020
Виды и формы кишечных инфекций
Возбудители инфекции, попадая в кишечник, начинают размножаться, отравляя организм токсинами, что приводит к появлению характерных тяжелых симптомов. Дети гораздо более восприимчивы к инфекциям, чем взрослые. Это обусловлено тем, что защитные силы организма у них слабее, микробы быстро распространяется по различным отделам более короткого кишечника. К тому же кислотность желудочного сока у ребенка ниже, чем у взрослого, поэтому жизнеспособность патогенных микроорганизмов выше.
Наиболее часто такие заболевания возникают у малышей в возрасте до 3 лет. Частые кишечные инфекции у ребенка могут стать причиной отставания его в физическом и психическом развитии. Особенно легко заражаются ослабленные дети.
Пути заражения и типы возбудителей
Основные пути передачи возбудителей – это контакт с больным или вирусоносителем, а также фекально-оральный (через воду, продукты, грязные руки и предметы быта), воздушно-капельный (через воздух, при кашле больного) и трансмиссионный (инфекцию распространяют грызуны и насекомые).
В особую группу выделяются пищевые инфекции, к которым относятся холера, дизентерия, сальмонеллез, вирусный гепатит А. Возбудители пищевых инфекций могут длительно сохраниться в таких продуктах, как яйца, сливочное масло, сметана, сыр, творог.
К пищевым инфекциям относят также так называемые зооантропонозы. Это бруцеллез, ящур, туберкулез, сибирская язва. Носителями инфекции являются животные. Заразиться можно, употребляя в пищу мясо и молоко (молочные продукты) больных животных.
Микроорганизмы-возбудители болезней
Возбудителями чаще всего являются бактерии. К ним относятся, например, дизентерийная палочка, вибрион холеры, сальмонелла, кампилобактерия. Если малыш физически крепок, у него достаточно сильный иммунитет, то большая часть бактерий нейтрализуется слюной, желудочным соком, подавляется полезной микрофлорой кишечника.
Предупреждение: Если ребенок плохо пережевывает пищу, ест на ходу, переедает, у него не успевает выделяться достаточное количество слюны, способной уничтожать вредные бактерии. Употребление щелочной минеральной воды снижает эффективность воздействия на них соляной кислоты желудочного сока. Антибиотики убивают полезную микрофлору, которая не дает развиваться патогенным микробам.
Существуют так называемые условно-патогенные бактерии (стафилококки, кишечные палочки), которые являются неотъемлемой частью естественной микрофлоры кишечника и не наносят вреда организму. Однако при неблагоприятных условиях (нехватке полезных лактобактерий, ослаблении иммунной защиты) они начинают усиленно размножаться.
Помимо бактерий, вызывать заболевания могут вирусы (ротавирусы, аденовирусы, энтеровирусы), простейшие микроорганизмы (амебы, лямблии), грибки.
Наиболее часто у детей встречаются такие инфекционные заболевания, как дизентерия, сальмонеллез, кампилобактериоз, ротавирусная, стафилококковая инфекция. Заболевание развивается у отдельно взятого малыша (спорадическое заражение), но нередко в детских учреждениях возникают вспышки (эпидемии) тяжелых кишечных инфекционных заболеваний, которые зачастую носят сезонный характер. Замечено, что пик заболеваемости дизентерией приходится на летне-осенний сезон, а ротавирусной инфекцией – на зиму.
Формы протекания
Кишечная инфекция у детей может развиваться в легкой, средней тяжести и тяжелой форме. В зависимости от того, насколько ярко выражены симптомы, протекание болезни может быть типичным и атипичным (со стертыми симптомами).
Возбудители могут поражать пищеварительный тракт не полностью, а лишь некоторые его отделы. В зависимости от того, в каком отделе желудочно-кишечного тракта развивается инфекция, выделяют следующие виды заболеваний:
- гастрит (воспаление слизистой оболочки желудка);
- дуоденит (воспаление двенадцатиперстной кишки);
- энтерит (поражение тонкого кишечника);
- колит (поражение толстого кишечника).
Очень часто возникают смешанные формы заболевания, например, гастроэнтерит, гастроэнтероколит.
Фазы течения болезней
В развитии кишечного инфекционного заболевания выделяют 3 фазы.
Острая фаза может длиться до 1.5 месяцев.
Затяжной называют фазу болезни, не прекращающейся через 1.5 месяца.
Хроническая – это фаза, при которой эпизоды заболевания периодически повторяются, так как инфекция продолжает оставаться в организме свыше 6 месяцев.


































